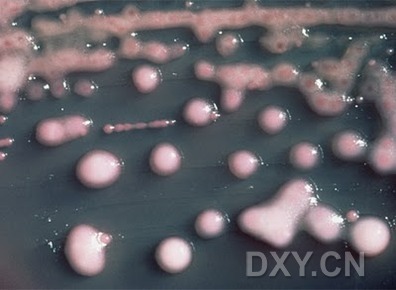

进出病房时用放置在床旁的杀菌水清洗双手是医院患者、医护人员以及探病者都熟知的常规。保持双手卫生能防止一些病菌感染,但即使是最好的卫生措施也不能阻止超级病菌,所谓的超级病菌是指那些对抗生素具有抵抗力的致死性菌株。
获得性医源感染是现今发达国家可预防死亡发生的主要原因之一,据世界卫生组织统计,仅在美国每年就有100000人死于从医院病人感染的病菌。老年人和幼儿是易受耐药菌感染的高危人群,在高危人群中耐药菌会如野火般凶猛地蔓延开来。
幸亏以色列的实验室工作人员研制出了一种基因工程洗液,这样我们就有了对付超级病菌的办法。
该种洗液对患者无毒并可涂在医院表面以杀灭传统清洁液和抗菌剂无法杀死的病菌。此报告的研究者是来自于特拉维夫Sourasky (Ichilov) 医疗中心的Rotem Edgar和特拉维夫大学的Udi Qimron。他们在应用与环境微生物学杂志上详述了他们的这项技术。
弱化超级病菌的抗生素抗性
该洗液利用了一种在实验室培育的被称为噬菌体的病毒,噬菌体可破坏具有抗生素抗性细菌的DNA结构而使细菌对抗生素易感。
“我们已经用基因工程手段改造了噬菌体,因此一旦它们侵染进细菌内,就转染了赋予细菌对特定的抗生素敏感的显性基因”,Qimron这样介绍说。他对自己研制的洗液终有一天会在所有医院应用深信不疑。
研究人员表示新型喷雾剂可应用于有大量细菌存在的任何表面除菌,例如门把手、水龙头、床栏杆和扶手等。
现在准备对该产品进行试验,首先将测试该喷雾剂对耐药性大肠杆菌的效果,大肠杆菌是一种可引起孕妇尿路感染的可恶细菌。科学家们还将测试这种喷雾剂对诸如甲氧苯青霉素耐药的金黄色葡萄球菌在内的其他种类耐药菌抗菌效果。
发明背后的科学研究
Edgar 和Qimron研究了细菌细胞内被称为蛋白质工厂的核糖体。有些种类的抗生素是通过粘附于核糖体使细胞失活发挥抗菌功能的。而有些细菌通过改变核糖体结构使抗生素不能与之结合而规避了抗菌药物的作用手段。
科学家们试图通过向细菌内加入一种对人体安全且能恢复细菌对抗生素敏感性的基因重新建立细菌敏感性和抗生素之间的联系,使得现有的抗生素可对超级病菌起效。
如果这种洗液可进行工业生产,那么产生的影响将是巨大的。
“我们的新型给药方式依靠有效的药物投递和选择性作用,这是此种给药方式第一次应用于抗菌液”Qimron说,他认为该产品将对所有种类的细菌有效,而且可降低非耐药性细菌感染率。
Qimron向以色列报社《Haaretz》的记者说:“人们能够用漂白剂杀死细菌,但是这并不能将细菌全部杀灭,而且诸如病人在病房中打喷嚏这类无法控制的事情使得耐药细菌重新在环境中播散。使用能够转变细菌对抗生素敏感性的药剂可阻止耐药菌在医院表面的繁殖,这对防治感染将是很有利的。”
根据研究者的介绍,这种洗液分两步有效地消灭医院内的细菌。过程的第二步是生成一种称为Tullurite的化合物。此物质可在表面扩散去杀死那些对新型药剂不敏感的残留细菌。该两步法清洗组合在消除细菌杀伤力之后继续发挥作用杀死那些尚有危险性的菌株。
同其他的医疗产品一样,这种新型的喷雾剂也需要通过临床机构的测试才可批准上市销售。







